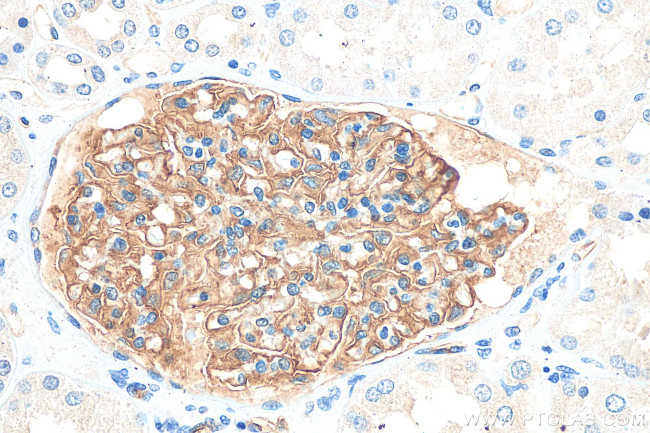
Podocalyxin Antibody in Immunohistochemistry (Paraffin) (IHC (P))

Search
Proteintech
Podocalyxin Monoclonal Antibody (4A3C7)
{{$productOrderCtrl.translations['antibody.pdp.commerceCard.promotion.promotions']}}
{{$productOrderCtrl.translations['antibody.pdp.commerceCard.promotion.viewpromo']}}
{{$productOrderCtrl.translations['antibody.pdp.commerceCard.promotion.promocode']}}: {{promo.promoCode}} {{promo.promoTitle}} {{promo.promoDescription}}. {{$productOrderCtrl.translations['antibody.pdp.commerceCard.promotion.learnmore']}}
产品信息
68250-1-IG
种属反应
宿主/亚型
分类
类型
克隆号
抗原
偶联物
形式
纯化类型
保存液
内含物
保存条件
运输条件
产品详细信息
Immunogen sequence: SPSPSPSPSQ NATQTTTDSS NKTAPTPASS VTIMATDTAQ QSTVPTSKAN EILASVKATT LGVSSDSPGT TTLAQQVSGP VNTTVARGGG SGNPTTTIES PKSTKSADTT TVATSTATAK PNTTSSQNGA EDTTNSGGKS SHSVTTDLTS TKAEHLTTPH PTSPLSPRQP TSTHPVATPT SSGHDHLMKI SSSSSTVAIP GYTFTSPGMT TTLPSSVISQ RTQQTSSQMP ASSTAPSSQE TVQPTSPATA LRTPTLPETM SSSPTAASTT HRYPKTPSPT VAHESNWAKC EDLETQTQSE KQLVLNLTGN TLCAGGASDE KLISLICRAV KATFNPAQDK CGIRLASVPG SQTVVVKEIT IHTKLPAKDV YERLKDKWDE LKEAGVSDMK LGDQGPPEEA EDRFSM
靶标信息
This gene encodes a member of the sialomucin protein family. The encoded protein was originally identified as an important component of glomerular podocytes. Podocytes are highly differentiated epithelial cells with interdigitating foot processes covering the outer aspect of the glomerular basement membrane. Other biological activities of the encoded protein include: binding in a membrane protein complex with Na+/H+ exchanger regulatory factor to intracellular cytoskeletal elements, playing a role in hematopoetic cell differentiation, and being expressed in vascular endothelium cells and binding to L-selectin.
仅用于科研。不用于诊断过程。未经明确授权不得转售。
篇参考文献 (0)
生物信息学
蛋白别名: GCTM-2 antigen; Gp200; MGC138240; PC; PCLP antibody; PCLP1 antibody; PODLX2; Podocalyxin; Podocalyxin-like protein 1; podolyxin; unnamed protein product
基因别名: gp135; Gp200; PC; PCLP; PCLP-1; PCLP1; PDX; PODXL; PODXL1
UniProt ID: (Human) O00592
Entrez Gene ID: (Human) 5420